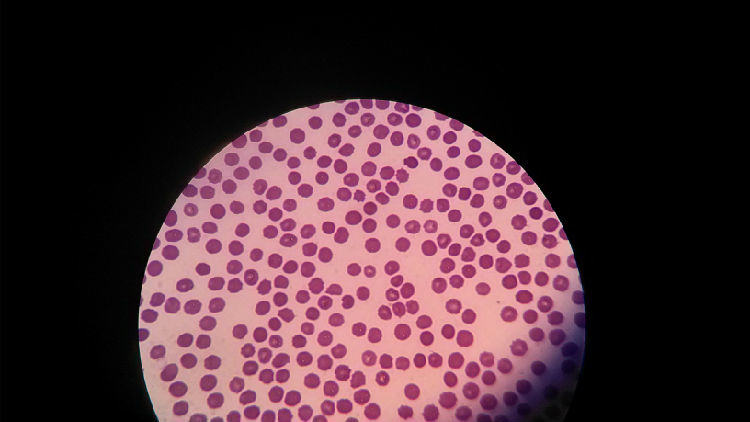
关于宠物贫血的症状及治疗 关于宠物贫血的症状及治疗

对于养宠物的主人,去医院做检查的时候,医生可能会说这只狗或猫存在贫血。但是大多数情况下都不会很重视这个问题。这个一方面是因为很多动物贫血比较常见,另一个原因可能是医生没有做详细的检查。其实贫血也是分很多情况的,我们需要综合的去看待这个问题。

患病狗狗
所谓贫血,指的是循环血液中的红细胞数或血红蛋白数低于正常值时的状态。贫血并不是一种单一疾病,更多的是一种或几种疾病的症候表现。导致贫血的原因很多,概括起来可以分为两种:红细胞生成不足或损耗过多。

患病狗狗
(口腔黏膜苍白,贫血的典型症状)
临床上见得最多的应该是小狗的营养性贫血,这个大多都是刚养宠物的主人在没有经验的情况下造成的,由于饲喂的不巧当不合理所导致的。解决方法很简单,小狗需要少量多餐以及高蛋白的食物。通俗的说就是让它"吃好"就行了。

化验数据
(血检单中RBC、HGB、HCT均低于正常值,典型的贫血检查结果)
红细胞生成减少,也叫再生障碍性贫血。导致这种贫血的原因很多,如骨髓造血机能下降或铁的利用障碍导致的血红蛋白生成障碍(严格意义上讲这种属于营养性贫血的范畴)。在再生障碍性贫血的血常规中可见RBC降低,而血涂片中却未见网织红细胞。

红细胞
(血涂片中红细胞中央淡然区扩大,多为缺铁性或出血性贫血的指示)
红细胞损耗过多分为两种情况,失血和溶血。
失血,又分为急性失血和慢性失血。判断依据首先可以根据动物的状态,急性失血多见于外伤,外科手术或者一些凝血机能不良情况。但是很奇怪的是这个时候的血检指标却可能显示正常。因为急性失血的第一个反应就是脾脏的收缩,使得外周血进入到循环池。这使得很多指标如HCT等会上升,然后又由于循环血的浓度升高,机体内的水分进入到血管内冲淡红细胞使得HCT又降到正常范围,接下来的72小时内,机体就会有一个代偿性的应答。在这种情况下的血涂片可见到红细胞大小不等,同时由于失血导致Fe的丢失,会看到很多低色素性红细胞(又叫小红细胞)。

患病狗狗
(细小因拉血导致的失血,细小的患犬病程中贫血严重)
溶血性贫血则可以分为红细胞自身原因的溶血性贫血,以及红细胞所处环境导致的溶血性贫血。前者大多是遗传性先天性的,后则有先天性也有后天性。见得比较多的原因有药源性的溶血(阿司匹林),生物源性的溶血(巴贝斯虫),中毒(铅中毒),以及一些原因导致的红细胞被氧化(吃了洋葱)。这个时候血涂片具有很重要的诊断意义。如看到巴贝斯虫,看到海恩次小体,球形红细胞增多等。
红细胞
(血涂片中可见大量的球形红细胞,多为溶血性贫血的指示)
贫血并不是一种病,而是一种临床表现。由于贫血会继发很多其他的情况,出现最多的就是心肺代偿的问题。机体由于贫血,使得血液运输氧气的能力下降,当没办法满足机体需求的时候,就会代偿性的呼吸加深,这就可能出现呼吸急促甚至喘的情况,而这种迫切想要吸入更多氧气的现象可能会出现呼吸性酸中毒的情况。同样的,由于机体贫血,机体很多组织器官满足不了对氧的需求,就会出现机能的障碍,最明显的就是大脑的机能障碍,可能出现头晕甚至抽搐等症状等。
由此,贫血虽不是一种准确的疾病名称,但是却可以指示出很多的问题,会对机体带来很多的负面影响,所以还是需要主人和医生的重视的。










